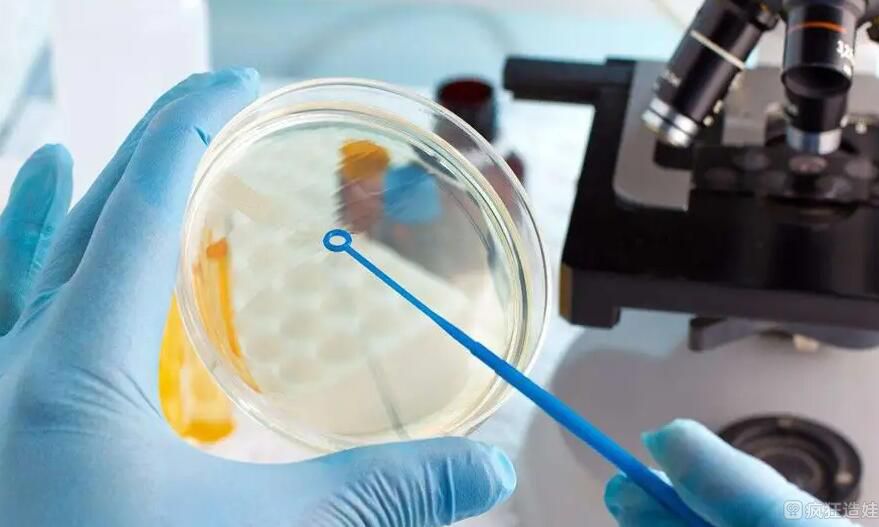
香港做第三代供卵试管婴儿包生男孩贵吗？二十万够吗？

-

供卵做试管多少钱?二十万够吗?
供卵做试管多少钱?二十万够吗?许多夫妇都有生育问题。虽然他们想通过自然分娩生孩子,但事与愿违。因为各种因素,夫妻只能选择试管婴儿来生一个自己的孩子。但是,还是有..
2022-12-22 16:05 -

高龄供卵试管多少钱?二十万够不够?
高龄供卵试管多少钱?二十万够不够?2022年我国公立医院试管婴儿捐献费用一般在3-8万人民币,少数成功率低的特殊患者费用略高,可能在10万人民币左右。其中一个捐赠的卵子..
2022-12-23 16:08 -

到底要不要生二胎 二十年后的六种结局给你答案
自从这二胎政策放开之后,大家就一直在讨论二胎究竟是生还是不生的问题。生吧,一是担心自己年龄大了,错过了最佳生育年龄,担心影响到孩子的健康;另外,如今的物价飞涨,..
2023-04-06 07:18 -

国内代怀生子需要多少钱?二十万够不够?
国内代怀生子需要多少钱?二十万够不够?要想清楚,就得一个一个算,因为试管婴儿的费用不是一次全算出来的,而是按照不同阶段来支付的,所以完成一个阶段还要再支付一个阶..
2023-04-09 11:14 -

长春三代试管包生男孩价格?二十万够吗?
长春三代试管包生男孩价格?二十万够吗?长春是吉林省的省会,简称长。在古代,它被称为西毒,茶冲,或被称为北方春城。很多人会选择在长春做第三代试管婴儿。有长春第三代..
2023-04-15 11:44 -

二十多个卵泡能取多少个
试管婴儿取卵个数的多少对妊娠率有一定的影响,所以很多患者对于取卵数都很关注。有些患者取卵十几个,甚至二十多个,而有的患者只有三五个,为什么会有这么大的差距呢?取..
2023-06-25 07:38 -

沈阳九州家圆医院供卵二代试管婴儿包男孩费用?二十万够吗?
沈阳九州家圆医院供卵二代试管婴儿包男孩费用?二十万够吗?沈阳九洲嘉园医院生殖中心设有生殖健康与专科,可开展夫精、供体人工授精、第一、婴儿技术等辅助生殖技术服务。..
2023-07-19 11:13 -
香港做第三代供卵试管婴儿包生男孩贵吗?二十万够吗?
香港做第三代试管婴儿供卵试管婴儿包贵吗?二十万够吗?怀上男孩,生下男孩,是一些求助试管婴儿的家庭的愿望。试管婴儿从一开始就帮助家庭有一个好的妊娠,而且更加优化。..
2023-08-16 11:45 -

广州第三代试管婴儿包生女孩价格?二十万够不够?
广州第三代试管婴儿包生女孩价格?二十万够不够?目前广州的第技术已经非常成熟,从技术上来说,第三代试管婴儿技术可以实现胚胎性别的选择,但从法律上来说,是无法实施的..
2023-08-22 11:54 -

重庆第三代试管婴儿选性别费用贵不贵?二十万够吗?
重庆第三代试管婴儿选性别费用贵不贵?二十万够吗?2022重庆总费用约为5-10万元。由于目前试管婴儿技术先进,成功率高,很多家庭在有生育需求时,往往会选择试管婴儿技术辅..
2023-08-25 12:40 -

【怀孕二十六周】怀孕26周胎儿图_孕妇饮食注意事项
要点提示:当孕妈妈进入怀孕26周时,肚子已经很大了。在这个孕周期不仅要关注胎儿的发育情况,胎动是否正常。还要合理的安排自己的日常饮食,牢记每一个怀孕注意事项,等待..
2023-09-03 08:50 -

【怀孕二十三周】怀孕23周胎儿图_孕妇胎动及饮食注意事项
要点提示:很多孕妈妈都知道按孕周期计算,但却不知道怀孕23周是几个月了。本文将介绍在这个怀孕周期,孕妈妈在生活上和饮食上要注意的事项,为你的宝宝保驾护航。怀孕二十..
2023-09-03 08:56 -

【怀孕二十四周】怀孕24周胎儿图_孕妇饮食注意事项
要点提示:你知道怀孕24周是几个月吗?你知道怀孕24周时胎儿有多大吗?在这个怀孕周期,孕妈妈的饮食生活注意事项,以及四维彩超图、胎动,本文都将为你一一详细介绍。怀孕..
2023-09-03 09:19 -

【怀孕二十周】怀孕20周胎儿图_孕妇饮食注意要点
要点提示:怀孕20周即是怀孕五个月了,此时的个孕周期胎儿发育已进入中期阶段,正是个关键时期,大脑开始划分专门的区域进行嗅觉、味觉、听觉、视觉以及触觉的发育。怀孕二..
2023-09-04 09:04 -

【怀孕二十二周】怀孕22周胎儿图_孕妇饮食注意事项
要点提示:孕妈妈进入怀孕第22周时,胎儿和妈妈都有什么变化了呢?本文接下来将为妈妈们详细介绍怀孕21周胎儿有多大,怀孕21周胎动情况,孕妇吃什么好及这个孕周期生活注意..
2023-09-04 09:10 -

【怀孕二十一周】怀孕21周胎儿图_孕妇饮食注意事项
要点提示:进入怀孕第21周的孕妈妈,此时的你已经怀孕五个月了,体重已增加了好几公斤,所以和孕前相比,会觉得笨拙很多。本周需要重点关注的是孕妇吃什么好及在生活上的注..
2023-09-04 09:13 -

2021年人造子宫有了最新消息:预计二十年后解决技术难题
子宫是女性特有的生殖器官,对调节女性生理健康和孕育后代有着重要作用,人造子宫就是模仿模拟哺乳动物子宫和卵生动物卵的条件,使受精卵在人造环境下发育的一种繁衍技术。..
2023-09-26 14:32 -
广东省妇幼保健院三代试管包男孩多少钱?二十万够吗?
广东省妇幼保健院三代试管包男孩多少钱?二十万够吗?广东省妇幼保健院IVF新鲜胚胎移植周期时间临床妊娠率为60%,冻融周期胚胎移植周期时间临床妊娠率为59%。其中,35岁以..
2023-09-28 19:22 -
贵阳三代试管生龙凤胎要花多少钱?二十万够吗?
贵阳三代试管生龙凤胎要花多少钱?二十万够吗?贵阳市妇幼保健院是云南省首获准开展辅助生殖技术的医疗机构。目前可以进行丈夫的人工授精技术,一代、第二代、第三代试管婴..
2023-09-28 19:52 -
广医三院生殖中心三代试管选性别生男孩多少钱?二十万够吗?
广医三院生殖中心三代试管选性别生男孩多少钱?二十万够吗?17年自然怀孕一个多月,自然流产。19年怀孕一个多月,发现胚胎不好。b超没有发现孕囊,后我做了清宫,做了病理..
2023-09-29 19:23
微信分享
扫描二维码分享到微信或朋友圈